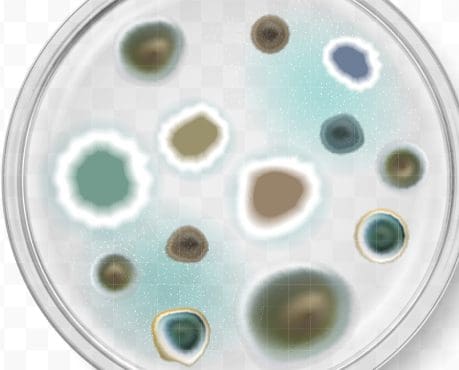
Asthme et moisissures : des associations mêmes pour de petites surfaces de moisi

Asthme et moisissures : des associations même pour de petites surfaces de moisi
- Accueil
- Nos actualités
- Asthme et moisissures : des associations même pour de petites surfaces de moisi
L’exposition aux moisissures est associée à l’asthme chez les volontaires de Constances et ce, même pour de petites taches de moisi dans le logement. Publiés en novembre 2025 dans Environmental Research, ces résultats encouragent la promotion de mesures préventives vis-à-vis de la contamination fongique : ventilation du logement, aération quotidienne même en hiver…
L’asthme est une maladie respiratoire fréquente qui touche plus de 4 millions de personnes en France dont environ 10 % des adultes. Elle peut considérablement altérer la qualité de vie, entraîner des insomnies, une baisse d’activité et un absentéisme à l’école ou au travail.
S’il est établi que le développement et l’aggravation de l’asthme sont favorisés chez les enfants par la présence de moisissures dans les logements, ces effets délétères sont peu documentés chez les adultes. La richesse des données de la cohorte Constances a permis d’apporter des réponses notamment grâce au questionnaire de suivi 2019.
Un peu ou beaucoup de surfaces atteintes chez les volontaires ?
Le questionnaire de 2019 comportait des questions sur les surfaces contaminées par des moisissures dans les logements. Plus de 110 000 volontaires y ont répondu. Publiées en 2023, les analyses descriptives réalisées par l’équipe d’épidémiologie respiratoire intégrative du Centre de recherche en épidémiologie et santé des populations (CESP) de Villejuif, ont montré que :
- 22 % des volontaires de la cohorte avaient des moisissures visibles dans leur logement. Cette fréquence est concordante avec celles des pays européens (autour de 25 %) et avec la dernière estimation en France datant de 2013 (entre 14 et 20 %).
- Les moisissures visibles étaient principalement localisées dans la salle de bain (chez 17 % des répondants). Cette fréquence était 2,5 fois supérieure à celle rapportée dans la chambre, la cuisine ou le salon (autour de 3,5 %).
- 2 % des volontaires ont indiqué une odeur de moisi dans leur logement.
- 0,3 % des répondants ont déclaré une surface moisie supérieure à 3 m².
« Nous avons aussi déterminé que l’existence de moisissures était associée à 4 déterminants du logement (avoir eu un dégât des eaux, avoir un logement difficile ou trop coûteux à chauffer, l’absence de système de ventilation, des taches d’humidité) et à 2 déterminants liés au comportement des répondants (ne pas aérer/ouvrir les fenêtres en hiver, avoir une fréquence de ménage inférieure à 1 jour par semaine) » indique Rachel Nadif, chercheuse Inserm au CESP qui a codirigé l’étude.

Conseils pour éviter les moisissures dans son logement
Le Ministère en charge de la santé met à disposition une brochure pédagogique et illustrée de conseils pour éviter et traiter les moisissures dans le logement. L'Agence de l'environnement et de la maîtrise de l’énergie (Ademe) propose également un guide de rénovation « Comment bien ventiler son logement ? ».
Croisement avec la santé respiratoire
L’équipe a ensuite croisé les données « moisissures dans le logement » avec les réponses du questionnaire « bilan de santé » complété par 28 596 volontaires lors de leur visite dans leur Centre d’examens de santé entre 2019 et 2022. Publiées dans Environmental Research en novembre 2025, les résultats montrent que même une petite surface de moisissures était associée à un risque accru d’asthme actuel (c’est-à-dire dans les 12 mois précédant le bilan de santé) ainsi qu’à un score de symptômes d’asthme plus élevé, comparativement aux logements sans moisissures. Ces associations ne différaient pas selon le type de logement (maison ou appartement) ou le sexe des répondants.
« Aucune étude ne s’était penchée jusqu’à présent sur des associations entre surface de moisissures et scores de symptômes d’asthme chez les adultes. C’était donc une première. Nous nous attentions à une association, mais pas forcément pour les surfaces les plus petites » indique Laurent Orsi, épidémiologiste-biostatisticien Inserm au CESP, qui a codirigé l’étude. Et d’ajouter : « La population de Constances est tellement grande que nous avons pu ajuster et tester énormément de facteurs. Tout était concordant ».

Ces résultats soulignent l’importance de la promotion des mesures préventives vis-à-vis de la contamination fongique : aération quotidienne (même en hiver), installation d’une ventilation, ménage hebdomadaire… Car si l’asthme est une maladie multifactorielle, l’exposition aux moisissures reste un facteur de risque évitable.
« En terme de santé publique, en terme d’inégalités sociales, ces résultats ont une répercussion car 22 % des volontaires ont déclaré des moisissures dans leur logement. Il est essentiel que les cliniciens demandent s’il y a des moisissures dans le logement lorsque leur patient est asthmatique » conclut Rachel Nadif.
Deux autres projets complémentaires sur l'asthme sont actuellement menés dans Constances :
- le projet NEMOD, auquel plus de 2 000 volontaires ont participé en plaçant dans leur chambre, pendant 4 semaines, des capteurs électrostatiques pour identifier les espèces fongiques et leur abondance.
- le projet MOLDASTH, qui s'intéresse à des voies biologiques de l’inflammation chez près de 2 000 participants à partir des échantillons issus de la biobanque de Constances.
Références bibliographiques :
Tajidine Tsiavia, Emilie Fréalle, Valérie Bex, Orianne Dumas, Marcel Goldberg, Nicole Le Moual, Celine Ribet, Nicolas Roche, Marine Savouré, Raphaëlle Varraso, Marie Zins, Bénédicte Leynaert, Rachel Nadif, Laurent Orsi. Mouldy area size and asthma symptom score and control in adults: the CONSTANCES cohort. Environmental Research. 2025. DOI: 10.1016/j.envres.2025.122254
Tajidine Tsiavia, Emilie Fréalle, Valérie Bex, Orianne Dumas, Marcel Goldberg, Nicole Le Moual, Celine Ribet, Nicolas Roche, Marine Savouré, Marie Zins, Bénédicte Leynaert, Laurent Orsi, Rachel Nadif. Determinants of mouldy area size in dwellings from the French CONSTANCES population-based cohort. Building and Environment. 2023. DOI:10.1016/j.buildenv.2023.110606
Thèse de Tajidine Tsiavia. Phénotypes inflammatoires de l’asthme : caractérisation, évolution et association avec l’exposition aux moisissures de l’air intérieur dans la cohorte Constances. 2023.
